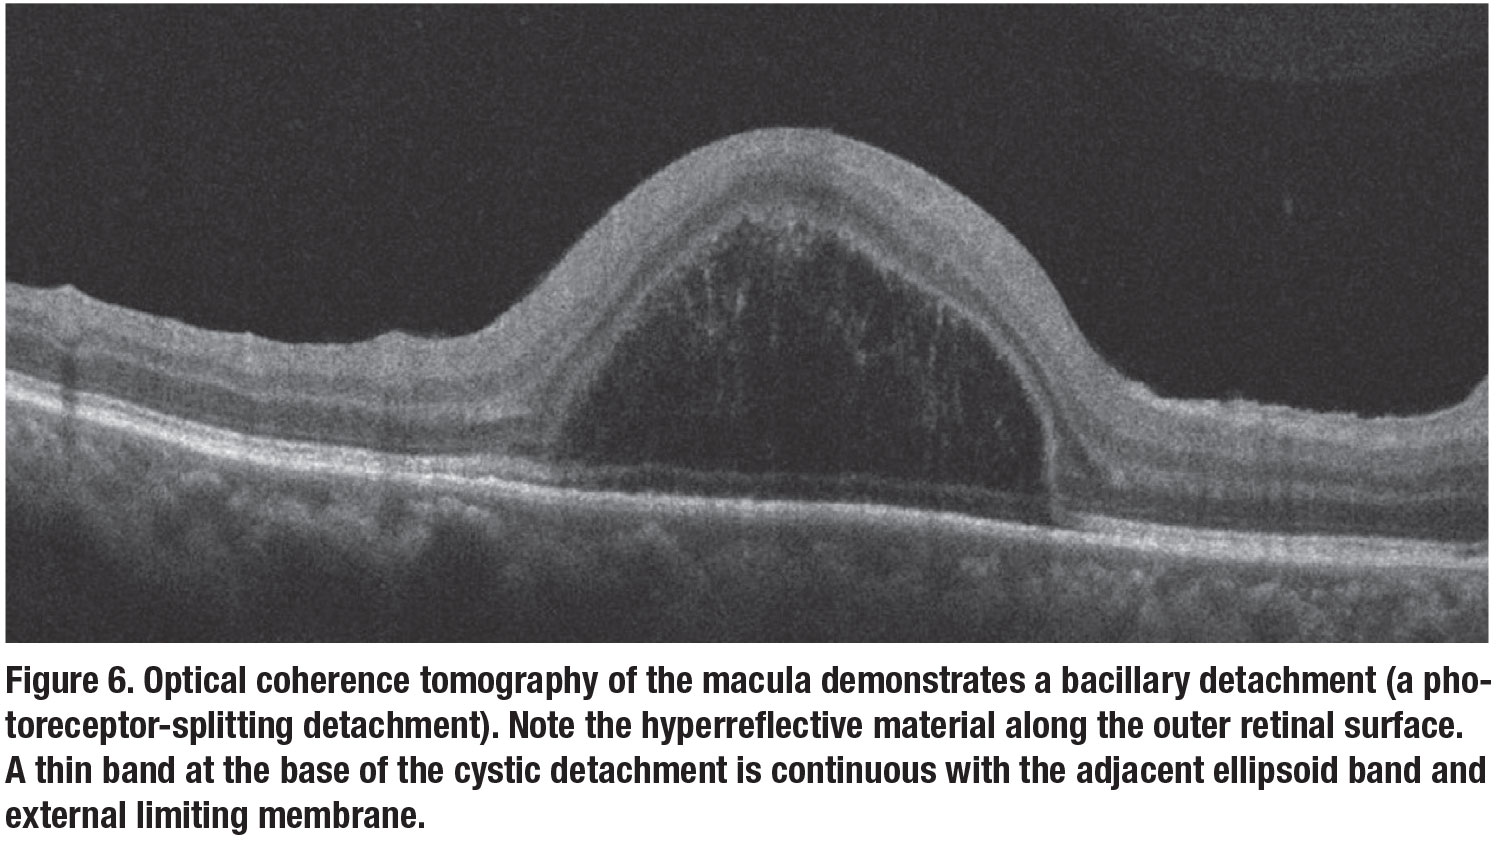

|
 |
 |
Spectral-domain optical coherence tomography is an essential tool for today’s practicing ophthalmologist. Most clinicians have come to rely on SD-OCT for the management and prognostications of various retinal pathologies, particularly diabetic macular edema, age-related macular degeneration and retinal vein occlusion, among other diseases.
However, beyond its ability to help with management and prognostication, OCT can play a significant role in the diagnostic process as well. In this article, we describe cases with “signature” OCT findings that helped lead us to the diagnosis.
All patients presented here were evaluated in the retina division of New York University Medical Center. This report is in accordance with the ethical standards of the Declaration of Helsinki.
Case 1: Choroidal neurofibromatosis
A 16-year-old girl presented for a routine eye exam and new glasses. She had no visual complaints and her best-corrected vision was 20/20 in both eyes. Near-infrared imaging of the macula demonstrated multiple hyperreflective round-to-ovoid lesions scattered throughout the posterior pole with corresponding cross-sectional B scans, localizing these lesions to the choroid (Figure 1).
Once considered a rare form of neurofibromatosis, choroidal neurofibromatosis was typically identified in post-mortem examinations due to difficulty visualizing the nodules with conventional ophthalmoscopy.
In 2000, researchers in Japan reported on the presence of bright patches on near-infrared imaging of the posterior pole of neurofibromatosis type 1 (NF1) patients that correlated with hypofluorescent regions on indocyanine-green angiography.1 Since then multiple publications have described the presence and prevalence of choroidal neurofibromatosis using OCT.2,3
Researchers at the University of Milan found that when using near-infrared imaging, choroidal neurofibromas were identified in up to 82 percent of NF1 eyes. Diagnostic accuracy increased to 90 percent in the general population when a cutoff of 1.5 nodules was used.3 In contrast, Lisch nodules and optic gliomas have a prevalence of 72 percent and 6 percent, respectively, in adult and pediatric patients combined.3
 |
 |
Despite their higher clinical prevalence, the diagnostic criterion for NF1 has yet to be updated to include choroidal neurofibromas. Nevertheless, the presence of bright lesions on near-infrared that correspond to hyperreflective choroidal lesions on OCT scans is a signature of NF1 (but not NF2), and should prompt further systemic exam to confirm the diagnosis. This case highlights the ability of OCT to aid in both phenotypic and genotypic diagnosis.
Case 2: Retrograde trans-synaptic degeneration
A 37-year-old man with a history of HIV and hemophilia presented for routine eye exam. Best-corrected visual acuity was 20/20 in both eyes. Slit lamp exam of the anterior and posterior segment was within normal limits.
Volumetric analysis of the OCT demonstrated slight thinning of the right nasal and left temporal macula respecting the vertical raphe (Figure 2, page 19). While OCT of the retinal nerve fiber layer was normal, OCT analysis of the retinal ganglion cell layer (GCL) confirmed marked thinning of the ganglion cell and inner plexiform layer in the same region (Figure 3).
 |
A 24-2 Humphrey Visual Field confirmed a dense right homonymous hemianopia (Figure 4). Further history taking revealed that the patient had a history of spontaneous cerebral hemorrhage as a toddler, which led to his ultimate diagnosis of hemophilia.
Severe injury to the nerve fibers within the visual cortex can result in nerve function loss. When this loss of function progresses toward the synapse to the presynaptic cell, this process is termed retrograde trans-synaptic degeneration (RTSD) of the retinal ganglion cell.4,5 One hypothesis is that this occurs due to the presynaptic dendritic tree no longer supplying trophic support to the injured cell.4
While RTSD was originally thought to occur in a “critical” window in early childhood or sooner, OCT imaging has identified cases in adults.5
In this case, segmentation algorithms in OCT analysis identified the loss at the GC-inner plexiform layer (IPL). It’s important to realize that an OCT of the RNFL, however, would be normal because the nerve fiber layer doesn’t degenerate in these cases.6
If OCT demonstrates volumetric loss of tissue in a homonymous pattern, consider GC-IPL analysis and visual field perimetry for confirmation of homonymous hemianopsia—a marker of brain injury that may warrant systemic management. After all, we are retinal specialists and the OCT precedes all else!
 |
 |
Case 3: Bacillary detachment
A 33-year-old man with a history of toxoplasmosis chorioretinitis presented with blurry vision and floaters in the right eye for one week. BCVA of the right eye was 20/200. Fundus exam demonstrated mild vitritis with a cluster of full thickness retinal whitening adjacent to a small hyperpigmented scar (Figure 5).
OCT of the macula illustrated a dome-shaped photoreceptor layer splitting detachment (Figure 6). Both the chorioretinitis and detachment resolved after treatment with antibiotics and steroid for one month.
OCT characterized the bacillary detachment, referencing this dome-shaped photoreceptor splitting, as a large cystic space within the outer retina that had hyperreflective material along the outer retinal surface and a thin band at its base that appeared continuous with the adjacent ellipsoid band or external limiting membrane.7 It’s theorized that the cystic space is located at the level of the photoreceptor inner segment myoid.7
Bacillary detachments have been reported in several other etiologies, most of which involve a compromise in the choroidal health. These etiologies
include central serous chorioretinopathy, Vogt-Koyanagi-Harada disease, adjacent-to-fibrovascular pigment epithelial detachments in exudative AMD, choroidal rupture and acute posterior multifocal placoid pigment epitheliopathy (APMPPE).8 So the presence of a bacillary detachment on OCT is useful in narrowing the differential diagnosis to a potential choroidopathy.
|
 |
Case 4: Photothermal damage
 |
An 8-year-old boy with type 1 diabetes presented with blurry vision in the right eye for the past two years. BCVA of the right eye was 20/80. Anterior segment exam was within normal limits. Fundoscopy was notable for a streak-like yellow foveal lesion (Figure 7).
Near-infrared OCT imaging revealed multiple tightly clustered, small bright round foveal lesions (Figure 8). OCT of the macula illustrated multiple focal areas of ellipsoid zone disruption corresponding to the bright lesions on infrared. The pattern of focal EZ loss was consistent with thermal injury from a laser pointer. The parents agreed that both the patient and his sister had laser pointers at home.
Ocular exposure to laser pointers can cause photothermal damage to the retina. Retinal
injuries range from photoreceptor disruption to photoreceptor and RPE disruption to full thickness macular holes.9 In the acute setting, OCT may demonstrate vertical or oblique lines of hyperreflectivity extending from the outer nuclear layer to the RPE. With time this hyperreflectivity can resolve, leaving behind focal outer retinal tissue loss.
Streak lesions are suggestive of self-inflicted laser pointer misuse, while focal lesions are suggestive of accidental or third-party-induced injury.9,10 Visual impairment can be transient or permanent depending on the intensity and duration of laser exposure. As the streak-like macular lesions suggested, our patient later admitted to a history of pointing a laser pen toward his right eye.
 |
 |
Bottom line
OCT imaging has indeed established its role in the management and prognostication of various retinal diseases. As we discussed here, it has the added benefit of illustrating signature findings that may aid in narrowing the differential diagnosis. While some of the findings may be subtle at first glance, these OCT features will hopefully remain indelibly in our memories for later recollection when a similar mystery patient presents. RS
REFERENCES
1. Yasunari T, Shiraki K, Hattori H, Miki T. Frequency of choroidal abnormalities in neurofibromatosis type 1. Lancet. 2000;356:988–992.
2. Nakakura S, Shiraki K, Yasunari T, Hayashi Y, Ataka S, Kohno T. Quantification and anatomic distribution of choroidal abnormalities in patients with type I neurofibromatosis. Graefes Arch Clin Exp Ophthalmol. 2005;243:980–984.
3. Viola F, Villani E, Natacci F, et al. choroidal abnormalities detected by near-infrared reflectance imaging as a new diagnostic criterion for neurofibromatosis 1. Ophthalmology. 2012;119:369–375.
4. Herro A, Lam B. Retrograde degeneration of retinal ganglion cells in homonymous hemianopsia. Clin Ophthalmol. 2015 Jun;1057.
5. Dinkin M. Trans-synaptic retrograde degeneration in the human visual system: Slow, silent, and real. Curr Neurol Neurosci Rep. 2017;17:16.
6. Mitchell JR, Oliveira C, Tsiouris AJ, Dinkin MJ. Corresponding ganglion cell atrophy in patients with postgeniculate homonymous visual field loss. J Neuroophthalmol. 2015;35:353–359.
7. Mehta N, Chong J, Tsui E, et al. Presumed foveal bacillary layer detachment in a patient with toxoplasmosis chorioretinitis and pachychoroid disease. Retin Cases Brief Rep. Published online August 23, 2018.
8. Cicinelli MV, Giuffré C, Marchese A, et al. The bacillary detachment in posterior segment ocular diseases. Ophthalmol Retina. 2020;4:454–456.
9. Alsulaiman SM, Alrushood AA, Almasaud J, et al. High-power handheld blue laser-induced maculopathy. Ophthalmology. 2014;121:566-572.e1.
10. Bhavsar KV, Wilson D, Margolis R, et al. Multimodal imaging in handheld laser-induced maculopathy. Am J Ophthalmol. 2015;159:227-231.e2.



